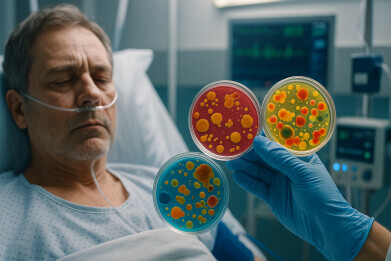
Global meta-analysis shows a third of hospital infections involve antimicrobial resistant bacteria

News
Global meta-analysis shows a third of hospital infections involve antimicrobial resistant bacteria
Nov 18 2025
A University of Leicester-led study has found that more than a third of hospital-acquired infections worldwide involve antibiotic-resistant bacteria, with affected patients facing a 58 per cent higher risk of death, highlighting urgent need for better surveillance and antimicrobial stewardship in hospitals, particularly in Africa, the Middle East and South Asia
Antimicrobial resistance (AMR) continues to pose a significant global health threat, with an estimated 1.14 million deaths worldwide annually directly attributable to bacteria that have become resistant to treatment with antibiotics. A study led by the University of Leicester has now shown that AMR in hospital settings is both widespread and independently associated with an increased risk of death.
The findings provide one of the most comprehensive global analyses made to date of the impact of drug-resistant infections in clinical settings. The research team drew on data from 34 hospital-based studies encompassing 20,658 patients across 18 countries. They found that more than one-third of hospital-acquired infections involved bacteria resistant to one or more antibiotics, representing a pooled prevalence of 36.5 per cent.
And worryingly, patients with resistant infections have a 58 per cent higher adjusted risk of death compared with those who contracted infections responsive to treatment. The highest mortality was seen among patients with bloodstream infections, underscoring the direct and immediate risk of AMR in acute care environments.
“Hospitals are high-risk environments for acquiring drug-resistant infections because many patients receive antibiotics and have invasive procedures,” said Dr Daniel Pan, infectious diseases clinician and National Institute for Health and Care Research (NIHR) Doctoral Research Fellow at the University of Leicester.
“Even in settings where effective antibiotics should be available, resistant infections still carry an independent increase in the risk of dying.
“AMR does not just threaten public health systems; it directly harms the individuals who acquire these infections,” he added.
Senior author Professor Manish Pareek, Chair in Infectious Diseases and Director of the Development Centre for Population Health at the University of Leicester, said:
“Our analysis also highlights major evidence gaps. Many under-represented regions, including parts of Africa, the Middle East and South Asia, had few or no eligible hospital-based studies linking AMR to mortality.
“If countries are to meet emerging United Nations goals on antibiotic access and reducing resistance, we urgently need better surveillance and more studies from these regions.”
The independent research was funded by global life reinsurance company Pacific Life Re and carried out with support from the NIHR Leicester Biomedical Research Centre (BRC). The authors stated that the views expressed were their own and not necessarily those of the funding bodies.
“It was great to collaborate with the University of Leicester on this meta-analysis which shows there is a lot more that can be done to quantify the potential impact of AMR in the future,” said Ian Collins, Vice-President for Medical Analytics at Pacific Life Re.
“This work has helped us to parameterise and calibrate our internal models and provides a valuable snapshot of the prevalence and lethality of resistant strains in hospital settings,” he concluded.
The NIHR Leicester BRC forms part of the NIHR and is hosted by the University Hospitals of Leicester NHS Trust in partnership with the University of Leicester, Loughborough University and the University Hospitals of Northamptonshire NHS Group.
For further reading please visit: 10.1016/j.eclinm.2025.103384
Digital Edition
Lab Asia Dec 2025
December 2025
Chromatography Articles- Cutting-edge sample preparation tools help laboratories to stay ahead of the curveMass Spectrometry & Spectroscopy Articles- Unlocking the complexity of metabolomics: Pushi...
View all digital editions
Events
Jan 21 2026 Tokyo, Japan
Jan 28 2026 Tokyo, Japan
Jan 29 2026 New Delhi, India
Feb 07 2026 Boston, MA, USA
Asia Pharma Expo/Asia Lab Expo
Feb 12 2026 Dhaka, Bangladesh